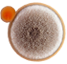

Antigen Products for Vaccine Development
Creative Biolabs can offer high-quality antigens for use in vaccine development that cover Viral Antigens, Parasitic Antigens, Bacterial Antigens, Tumor antigens and so on. In immunology, an antigen is a molecule capable of inducing an immune response (to produce an antibody) in the host organism. Creative Biolabs provides dozens of antigens for your vaccine development (including using as an immunogen) and serological based diagnostic tests with fairly good sensitivity and specificity. All antigens have sufficient inventory with good quality to ensure fast delivery service worldwide and we offer quantity discounts. Welcome enquiry, please email list for unit or inquire!
Protein Expression Services
In addition to the below-mentioned catalogue antigen products, Creative Biolabs relies on its well-established expression systems with a rich content including E. coli, yeast, baculovirus-insect, mammalian cells and plant expression systems to express either complex folded or different post-translationally modified proteins according to the actual needs of customers.
• Gene optimization: genes synthesis, vector construction
• Vector construction
• Screening of expression strains
• Small-scale expression
• Protein expression optimization
• Large-scale expression and purification
• Protein folding, modification, renaturation, endotoxin detection and removal
• Protein identification
After the initial consultation, we will develop a project plan based on your specific requirements and define milestones and reports at each step. To minimize project risk and overall cost, we usually conduct small-scale protein expression tests to assess project feasibility before scaling up to purify large quantities of the desired protein. Please contact us for more details!
 Viral Antigens
Viral Antigens
 Bacterial Antigens
Bacterial Antigens
Fungal Antigens
Fungal Antigens
 Parasite Antigens
Parasite Antigens
 Tumor Antigens
Tumor Antigens
 Drugs of Abuse-Antigens
Drugs of Abuse-Antigens
All of our products can only be used for research purposes. These vaccine ingredients CANNOT be used directly on humans or animals.


